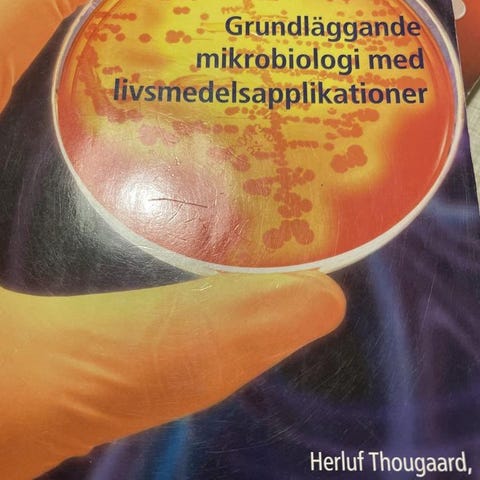
Annonsbild

Kan skickas
Frakt från 39 kr + köpskydd 24 kr
Varan skickas till dig. Du har 24 timmar på dig att kontrollera varan innan pengarna överförs till säljaren.
Skick: Bra skick - varsamt använd
Upplaga: 4e upplagan
Utgiven: 2009
ISBN: 9789147084463
Sidor: 400 st
Förlag: Liber
Format: Häftad
Språk: Svenska

Du måste vara inloggad för att se användarprofiler och skicka meddelanden.
Logga inSenast ändrad: 8.10.2025 kl. 19:40 ・ Annons-ID: 17906184